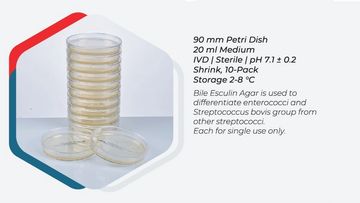

PREPARED MEDIUMS
Petri Dish

Prepared 5% Sheep Blood Agar

Prepared EMB Agar

Prepared Mueller Hinton Agar

Prepared Chocolate Agar

Prepared Saboraud Dextrose Agar

Prepared Macconkey Agar

Prepared Campylobacter Selective Agar

Prepared Hektoen Enteric Agar

Prepared 5% Sheep Blood Mueller Hinton Agar

Prepared Salmonella Shigella Agar

Prepared 5% Sheep Blood Schaedler Agar

Prepared Endo Agar

Prepared Thayer-Martin Agar
Prepared Bile Esculin Agar

Prepared Mannitol Salt Agar

Prepared Chromogenic Candida Agar

Prepared Chromogenic MRSA Agar

Prepared Chromogenic UTI Agar

Prepared Chromogenic KPC Agar

Prepared Brain Heart Infusion Agar

Prepared VRE Agar

Prepared Mueller Hinton Agar 120 MM

Prepared SDA + Cycloheximide Agar

Prepared SDA + Gentamicin + Chloramphenicol Agar

Prepared Potato Dextrosel Agar

Prepared Tryptic Soy Agar

Prepared Corn Meal Agar

Prepared 5% Sheep Blood + Chocolate Agar

Prepared 5% Sheep Blood + UTI Agar

Prepared DNASE Agar

Prepared 5% Sheep Blood + EMB Agar
Tube

Prepared MR-VP (Clark Lubs) Broth

Prepared S.I.M. Medium Media

Prepared Thioglycolate + VIT K + Hemin Media

Prepared Urea Agar

Prepared MIO Medium Agar

Prepared TSI Agar

Prepared Indol Broth

Prepared Brain Heart Infusion Broth

Prepared Selenit F Broth

Prepared Mueller Hinton Broth

Prepared Tryptic Soy Broth

Prepared Saboraud Dextrose Broth

Prepared Nutrients Broth

Prepared EE Broth

Prepared Thioglycolate Tube Medium

Prepared Gram Negative Tube Medium

Prepared Simons Citrate Agar
Cookies are used on this website.
We use cookies to analyze website traffic and optimize your website experience. When you agree to our use of cookies, your data is collected together with all other user data.